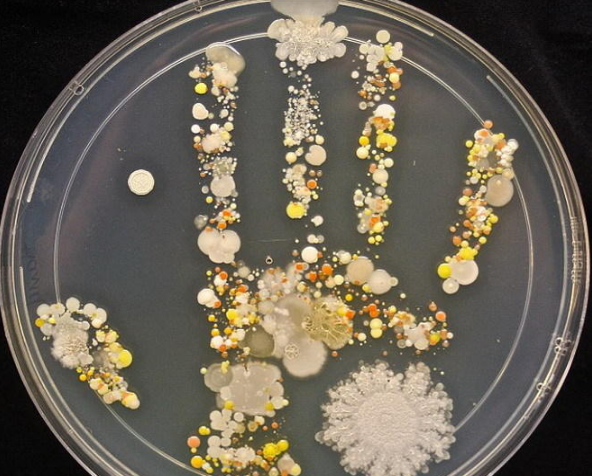
图片

大家都知道现在疫情尚未过去,还不能够掉以轻心,手部卫生对于预防病毒传播依旧极为重要。
但是就在前段时间,一则关于韩国的问题免洗手消毒液流入中国市场的新闻进入大家的视野。

如果不慎用到了不过关的产品,更是让原本就不干净的手“雪上加霜”。有人说那就不用了呗,直接用水冲洗。
可是孩子每次在水龙头前随便划拉几下,你以为手湿了就等于洗干净了吗?
下面这个是美国微生物学家塔莎做的一个实验。

手无时无刻都在接触脏东西,一天下来会附着4万—40万个细菌,简直比泡在马桶里还要脏。
想象下你的孩子,如果用这一双脏兮兮的手吃东西,揉眼睛,这到底有多糟糕!
单纯用水“假装洗手”,根本就无法彻底撵走病菌。
比如疫情期间,孙俪娘娘就深切体验“喊了800遍让娃洗手”的抓狂,4个省略号,真实的心理斗争,小编都感受到了她的歇斯底里。

想让娃爱上洗手?其实很简单,我们热卖的恐龙水晶皂,就能让99%的小朋友都爱上洗手洗爸爸的臭袜子哈哈~
海洋水晶皂
看,这就是海洋水晶皂,一股海洋清新风,无论男宝女宝都会被迷住吧~
再次跟大家声明,水晶皂的原料皂基,不含荧光剂和酒精,孩子洗手不伤手还润肤,可是货真价实的上等皂基哦,麻麻们放心吧~

体验员们都玩的超happy,看丰宝开心得脸都变形,边玩边说:鲨鱼,来咬你们了▼
小女孩做完还要慢慢欣赏,每一个都是心爱的宝贝▼

终于等到脱模了,露出了大丰收的喜悦感▼
水晶皂制作起来不复杂,小朋友几乎能独立完成,来看看~



2.向一次性塑料杯中放入少量皂基,不要超过半杯。
3.把塑料杯放在大碗中,隔水加热搅拌直至融化。
这就是皂基融化后的样子,已经变成液状了👇
4.给皂基溶液中滴上2滴甘油、适量香精、色素(少于2滴)。
6.将水晶皂放入礼品袋中,一份高颜值又实用的心意礼物就完成了。
别说小孩了,乔麻都唤起了久违的童心,成就感满满,看鱼群来了~



培养动手能力,精细手部动作
4.5岁的婷宝加色素、香料、甘油独立完成,完全沉浸在欢乐的手工世界里▼
加入色素后水晶皂变成黄色,露出惊讶的表情,太逗了▼


丰宝洗手史无前例地多,8次+/天,每次饭前或手脏了自己跑去洗,根本不用督促▼

我们附赠的22个精美礼品袋和12张礼物属性的动物卡片,就是希望孩子从小学会“分享”。
自己DIY的海洋动物,当做小礼物送给同学朋友老师,不仅能学会大方的心态,更能促进好人缘~

认认真真包扎好,就可以送出去了▼
黄色的海星,红色的海马送给哪个好朋友呢,小朋友心里早有数了▼


而且,比第1代优化了不少,比如画风更加舒服,颜色搭配简约美观。


看,霖霖小朋友每一页都看得津津有味,肥皂来历的故事一定让她大开眼界吧~
你问我答
问:一盒玩具能做多少块交通工具肥皂呢?
答:模具一次能做12块,起码能做2次,也就是24块~
问:这些香精和色素都是无害的吗?
答:没错!这类玩具的原料,我们都采用食品级无害材料制作,孩子是可以放心玩的!
问:家里的娃年龄还小了点,皂基和水晶皂能保存多久啊?
答:皂基起码可以存放一年甚至更久,制作好的水晶皂可以存放更久。
问:礼品袋感觉不够送啊怎么办?
答:可以让孩子好好考虑先送给谁,另外礼品店也有这种小礼品袋售卖的~
